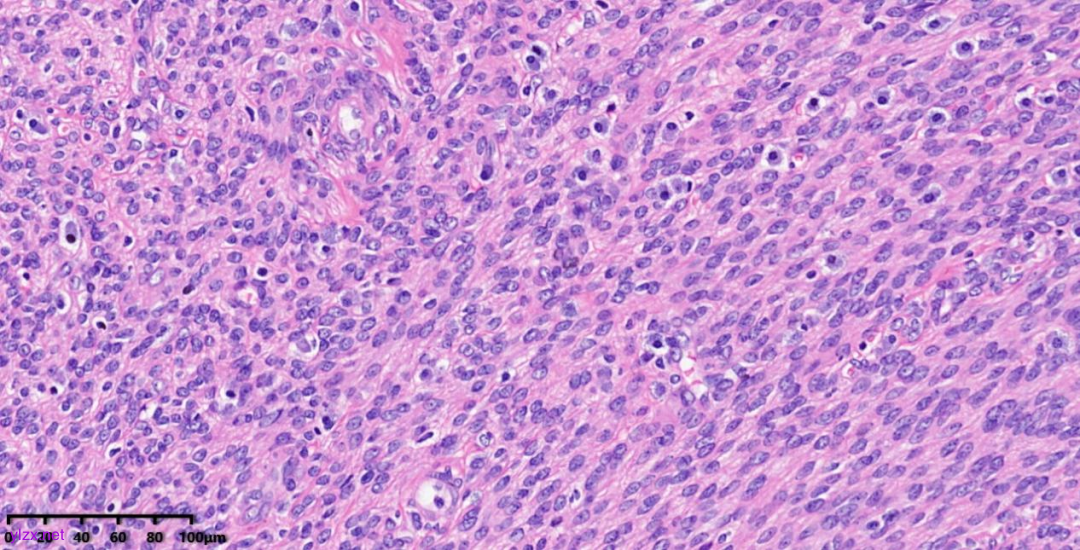
图片
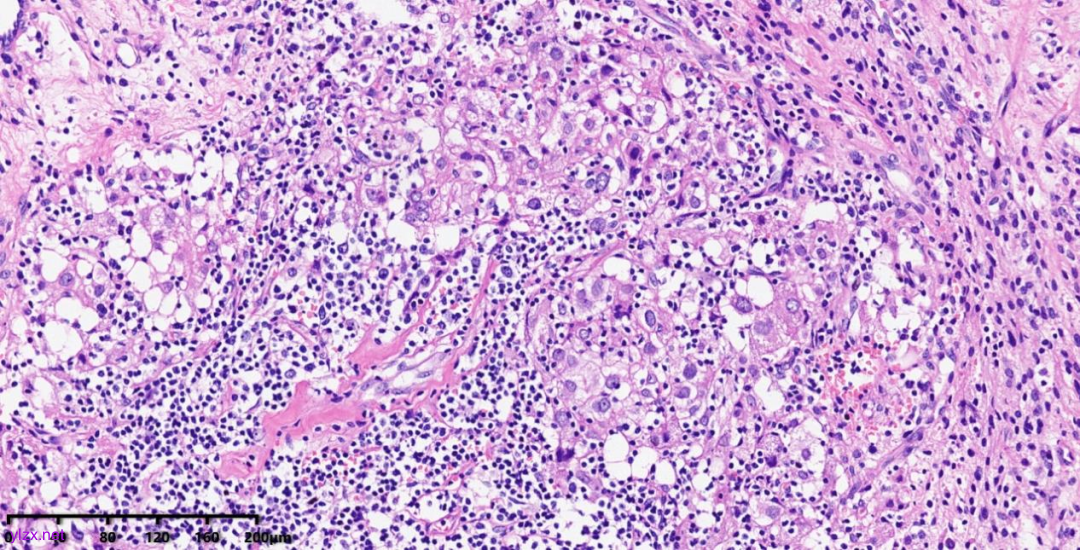
图片

病例分享 | 子宫阔韧带巨大PEcoma一例
时间:2025-04-24 12:11:07 热度:37.1℃ 作者:网络
01 病 史
49岁,女性,1周前超声体检发现盆腔巨大占位,偶有腹胀,无明显腹痛。子宫增大如孕6个月。既往史:3年前左肺浸润性腺癌行肺段切除手术。
02 辅助检查
实验室检查:
CA125 82U/ml。
MRI检查:
子宫右侧巨大实性占位,大小约260×110×91mm,与子宫分界不清,T1WI呈稍低信号,T2WI呈不均匀稍高信号,呈束状、旋涡状改变(图1),病变内部分可见囊变,肿瘤内部及表面多发流空血管影(图2);DWI上病变呈略高信号,ADC图呈略低信号,ADC值为1.633×10-3 mm2 /s;增强扫描呈明显强化(图3),内部见条片状低信号。影像学考虑子宫右侧恶性肿瘤。

图1

图2

图3
03 手术所见
术中见腹腔巨大肿瘤,来源于子宫右侧阔韧带,多枚融合,部分呈囊性,肿瘤大小约30cm,部分肠管致密粘连于瘤体,子宫体多发性平滑肌瘤,子宫增大如孕4月,双侧骨盆漏斗韧带粗大,腹腔少量淡黄色积液约50mL。
04 病理大体检查
子宫体、宫颈右侧壁、右阔韧带区见巨大多结节状肿块一枚,大小32X14X9cm,表面尚光滑,有灰红色包膜,切面大部分呈实性,灰黄、灰红色,质稍软,束状、旋涡状纹理,局部呈囊性,内含淡红色液体,部分区边界不清。子宫左侧肌壁间见肌瘤样结节一枚,大小8.9x8.7X8cm,界限清楚,切面灰白色,小区灰红色,质韧偏软,编织状纹理。

子宫体、宫颈右侧壁、右阔韧带区肿瘤大体形态
05 镜下组织形态:
肿瘤细胞以梭形细胞、卵圆形细胞为主,部分为胞浆透亮的上皮样形态,透亮细胞界限较清,胞质淡染或胞浆丰富、嗜酸性,肿瘤内血管丰富,肿瘤细胞围绕血管周围片巢状、束状及放射状排列;肿瘤细胞核异型性不明显,核分裂像少见(<1个/50HPF),染色质开放,可见小核仁;肿瘤间质水肿、黏液变性,纤维胶原增生伴玻璃样变性。

图1

图2

图3

图4

图5
图1~5 低倍镜下:肿瘤细胞以梭形细胞、卵圆形细胞为主,部分为胞浆透亮的上皮样形态,肿瘤细胞分布疏密不均,部分区密集丰富,部分区肿瘤细胞稀少,间质疏松水肿、黏液变性,肿瘤细胞围绕血管周围生长,局部间质纤维胶原增生伴玻璃样变性。

图6 中倍镜下:肿瘤内血管丰富,胞浆透亮的上皮样细胞围绕血管周围片巢状、束状及放射状排列。

图7
图8

图9
图10
图7~10 高倍镜下:梭形细胞、上皮样细胞组成的巢状、梁状结构,周围包绕纤细的薄壁毛细血管,肿瘤细胞呈放射状排列在血管周围,细胞界限较清,胞浆丰富、嗜酸性或透亮,细胞异型性不明显,核分裂像少见,细胞核呈圆形,染色质开放,可见小核仁;局部少量慢性炎细胞浸润。
06 免疫组化:
HMB45、Desmin、Caldesmon、SMA、ER、PR、CD10阳性表达,MeLanA、Cyclin D1阴性,ki-67增值指数低(约2%)。

图11 肿瘤细胞HMB45胞浆阳性

图12 肿瘤细胞Desmin胞浆阳性

图13 肿瘤细胞caldesmon胞浆阳性

图14 肿瘤细胞CD10胞浆阳性

图15 肿瘤细胞Ki67增值指数低
07 最终病理诊断:
该肿瘤经充分取材未见凝固性坏死,未见淋巴管及血管侵犯,经鉴别诊断排除其他间叶源性肿瘤后,病理诊断为血管周上皮样细胞肿瘤(PEComa),但本例肿瘤巨大,肿瘤边界呈推挤状及舌状浸润性生长,多灶性浸润子宫肌壁,提示肿瘤恶性潜能未定,需注意密切随诊。
08 致谢:
本例最终诊断衷心感谢上海市临床病理读片会特聘专家王坚教授的指导与帮助!
讨 论
【定义】:
血管周上皮样细胞肿瘤(Perivascular epithelioid cell tumor ,PEComa)是一种起自于血管周上皮样细胞(PECs)的间叶性肿瘤,通常与血管壁密切相关,常显示联合性肌色素细胞免疫表型。PEComa家族包括发生于一些特殊脏器的临床亚型:血管平滑肌脂肪瘤(AML)、肺透明细胞糖瘤(CCST)、淋巴管肌瘤病(LAM)。
【ICD-O编码】:
8714/0
【发病部位】:
PEComas可发生于任何部位,如腹膜后、腹腔、盆腔、子宫、胃肠道、肾脏、肝脏、肺,少见于四肢、骨和皮肤。女性生殖系统PEComa最好发于子宫,大多数位于宫体,少数位于宫颈,偶可发生于阔韧带、圆韧带及阴道。子宫PEComa可合并肺和肾AML。
【临床特征】:
女性生殖系统PEComa患者年龄范围9~79岁(平均年龄45岁)。临床症状
包括不规则阴道流血和下腹部疼痛,病情严重者可有腹腔积血甚至子宫破裂,也可无任何症状,体检时偶然发现。
【影像学检查】:
子宫PEComa影像学表现各异,其MRI表现具有一定的特征,肿瘤T2WI信号稍高,呈束状排列,富血供,可伴有变性、坏死,肿瘤内部及表面可见多发流空血管影。
【病因/发病机制】:
TSC1/TSC2失活突变导致mTOR通路信号传导上调;AML、CCST和LAM与结节性硬化综合症相关;其他多数PEComas为散发性。
【大体形态】:
肿瘤大小不等,直径0.3~25cm,平均为8cm,切面灰白色、灰褐色,大部分境界清晰的肿瘤,质偏韧。
【镜下组织形态】:
PEComas通常表现为由梭形细胞、上皮样细胞组成的巢状、梁状结构,具有丰富的颗粒状、嗜酸性或透亮胞浆,圆形细胞核及细小核仁,巢状、梁状结构周围通常包绕纤细的薄壁毛细血管,肿瘤细胞呈放射状排列在血管周围。
Vang 和Kempson将子宫PEComa分为两组:A组肿瘤境界不清,镜下显示成巢或成片的透明细胞,细胞内偶可见色素,肿瘤呈舌状(tongue-like)生长,类似子宫内膜间质肉瘤;B组肿瘤境界清楚,镜下透明细胞较少,瘤细胞的胞质可呈嗜伊红色,上皮样瘤细胞呈梁索状排列在致密的胶原纤维中,间质可呈明显玻璃样变,也称硬化性PEComa。PEComa通常无或少见有丝分裂,部分可见肿瘤细胞轻度多形性。部分病例内可见多核瘤巨细胞,偶可完全呈多形性肉瘤样,易被误诊为子宫内膜间质肉瘤、未分化肉瘤或转移性恶性黑色素瘤。恶性PEComas的特点是表现为有丝分裂象活跃、可见坏死及多形性。
【免疫表型】:
PEComas表达黑色素细胞标记(如HMB45、melan-A和MITF)以及肌源性标记(如SMA、desmin和caldesmon),Desmin和h-caldesmon的阳性程度往往低于SMA。A组瘤细胞主要表达HMB45,而很少表达肌源性标志物;B组瘤细胞主要表达肌源性标志物,小部分表达 HMB45。黑色素细胞标志物表达在上皮样肿瘤细胞中比在梭形肿瘤细胞中更常见。子宫肉瘤样PEComa以表达色素细胞标记为主。大约15%的病例的肿瘤细胞TFE3核强阳性,TFE3重排的PEComas多发生在年轻患者中,具有显著的腺泡状生长模式和上皮样形态,并且经常不表达平滑肌标志物。
【治疗】:
完整切除;长期随访;恶性PEComa采用mTOR抑制剂(如西罗莫司)可能会有一定的疗效。
【预后】:
子宫 PEComa预后很不明确,病例之间存在一定差异,大部分预后较好,其中有不少病例在临床上呈侵袭性,最常见的转移部位是肝脏、淋巴结、肺和骨骼。倾向于具有侵袭性的临床行为的特征有:显著的细胞异型性和多形性,有丝分裂活跃,出现坏死及浸润性边缘;肿瘤最大径>5cm也与复发显著相关。
【鉴别诊断】
1、平滑肌肿瘤:肌瘤样PEComa容易被误诊为平滑肌瘤,与梭形细胞为主的PEComa在形态上可有重叠,主要条束状排列的嗜酸性梭形细胞组成,核呈雪茄样。当瘤细胞显示有一定异型性时,可被误诊为平滑肌肉瘤。但是平滑肌肿瘤表达肌源性标记物,不表达HMB-45、MART-1及MITF。另一方面,肌瘤样PEComa中一些厚壁血管及血管壁周围少量放射状排列的上皮样或梭形PEC细胞多提示PEComa。
2、子宫内膜间质肿瘤:部分子宫内膜间质肿瘤与PEComa相似,尤其是HGESS易与恶性PEComa混淆,且部分PEComa还可表达CD10,比如本例。形态学上PEComa除短束状排列的梭形细胞,还有巢状分布的上皮样细胞,可有透明或嗜酸性颗粒状细胞质,间质有玻璃样变,肿瘤血管从毛细血管网到厚壁大血管不等,黑色素瘤标志物和平滑肌标志物如HMB45、Melan A、MiTF不同程度共表达,可与子宫内膜间质肿瘤鉴别。
3、恶性黑色素瘤:临床上可有恶黑病史,肿瘤细胞通常呈现出弥漫片状的排列方式,细胞形态学特征多样,从未分化到上皮样、梭形、浆细胞样和横纹肌样不等,并且一些细胞常具有偏心的细胞核、显著的核仁以及胞质内黑色素沉着。肿瘤细胞表达S-100、SOX10,肌源性标记阴性。
4、浸润性/转移性癌:特别是肾细胞癌、肾上腺皮质癌及肝细胞癌,肿瘤与血管壁关系不密切,表达上皮标记,不表达肌源性和色素性标记。
*本文(包括图片)均为作者投稿, 仅供行业交流学习用,不作为医疗诊断依据。
参考文献
[1] 中国医师协会微无创医学专业委员会妇科肿瘤学组, 中国抗癌协会妇科肿瘤专业委员会. 女性生殖道血管周上皮样细胞肿瘤诊治的中国专家共识(2023年版). 癌症进展, 2023,21(16):1741-1746,1750.
[2] 赵明, 何向蕾, 曹登峰. 女性生殖道血管周上皮样细胞肿瘤的诊断及鉴别诊断进展. 中华病理学杂志, 2021,50(9):1083-1087.
[3] Nishio N, Kido A, Minamiguchi S, et al. MR findings of uterine PEComa in patients with tuberous sclerosis: report of two cases. Abdom Radiol (NY), 2019,44(4):1256-1260.
[4] Kwon BS, Suh DS, Lee NK, et al. Two cases of perivascular epithelioid cell tumor of the uterus: clinical, radiological and pathological diagnostic challenge. Eur J Med Res, 2017,22(1):7.
[5] Tirumani SH, Shinagare AB, Hargreaves J, et al. Imaging features of primary and metastatic malignant perivascular epithelioid cell tumors. AJR Am J Roentgenol, 2014,202(2):252-8.
[6] Phillips CH, Keraliya AR, Shinagare AB, et al. Update on the imaging of malignant perivascular epithelioid cell tumors (PEComas). Abdom Radiol (NY), 2016,41(2):368-76.
[7] Nie P, Wu J, Wang H, et al. Primary hepatic perivascular epithelioid cell tumors: imaging findings with histopathological correlation. Cancer Imaging, 2019,19(1):32.
[8] WHO Classification of Tumours of Soft Tissue and Bone Tumours. 5h Edition.
[9] Diagnostic Pathology: Soft Tissue Tumours (3 rd Edition).

